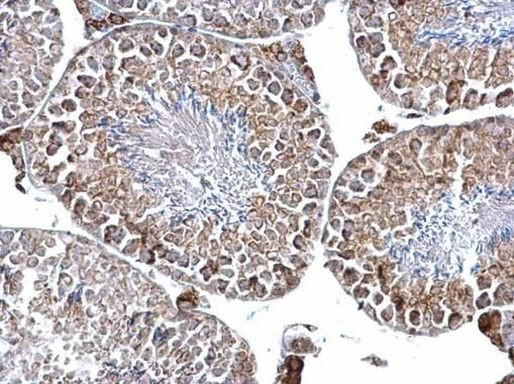
DGAT2 Antibody in Immunohistochemistry (Paraffin) (IHC (P))

Search
Invitrogen
DGAT2 Polyclonal Antibody
{{$productOrderCtrl.translations['antibody.pdp.commerceCard.promotion.promotions']}}
{{$productOrderCtrl.translations['antibody.pdp.commerceCard.promotion.viewpromo']}}
{{$productOrderCtrl.translations['antibody.pdp.commerceCard.promotion.promocode']}}: {{promo.promoCode}} {{promo.promoTitle}} {{promo.promoDescription}}. {{$productOrderCtrl.translations['antibody.pdp.commerceCard.promotion.learnmore']}}
产品信息
PA5-21722
宿主/亚型
分类
类型
抗原
偶联物
形式
浓度
规格
保存条件
运输条件
RRID
产品详细信息
PA5-21722 targets DGAT2 in IHC (P) and WB applications and shows reactivity with Human and mouse samples.
The PA5-21722 immunogen is a recombinant fragment corresponding to a region within amino acids 153 and 388 of DGAT2 (Uniprot ID#Q96PD7).
靶标信息
Acyl-coenzyme A:diacylglycerol acyltransferase, also known as DGAT1 and ARGP1, is a microsomal enzyme that assists in the synthesis of fatty acids into triglycerides. DGAT1 catalyzes the terminal and only committed step in triacylglycerol synthesis by using diacylglycerol (DAG) and fatty acyl CoA as substrates. DGAT1 plays a fundamental role in the metabolism of cellular diacylglycerol and is important in higher eukaryotes for physiologic processes involving triacylglycerol metabolism, such as intestinal fat absorption, lipoprotein assembly, adipose tissue form-ation and lactation. DGAT2, which has no homology to DGAT1, differs from DGAT1 in that its activity has been shown to be inhibited by MgCl in an in vitro assay. DGAT2 is expressed primarily in liver and white adipose tissue, which suggests that it plays an important role in mammalian triglyceride metabolism.
⚠WARNING: This product can expose you to chemicals including mercury, which is known to the State of California to cause birth defects or other reproductive harm. For more information go to www.P65Warnings.ca.gov.
仅用于科研。不用于诊断过程。未经明确授权不得转售。